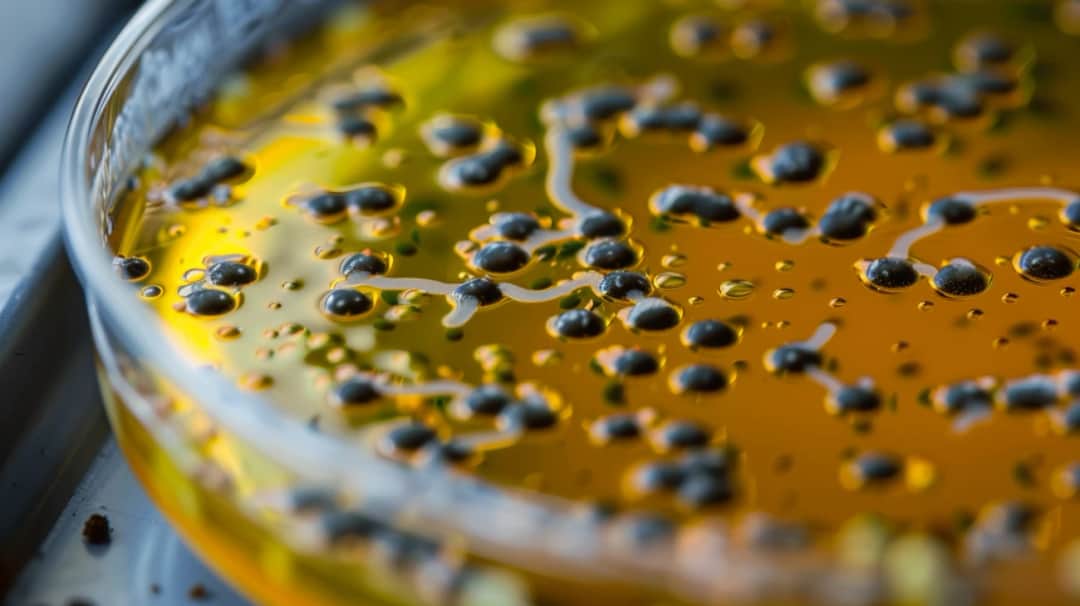
Clostridium - co warto wiedzieć o groźnej bakterii?

Co to rzs? Dowiedz się, czym jest reumatoidalne zapalenie stawów - przewlekła choroba autoimmunologiczna atakująca tkanki stawowe. Sprawdź definicję, przyczyny, objawy i leczenie rzs
Jestem założycielem i głównym autorem portalu o zdrowiu, który powstał z mojej pasji do medycyny i zdrowego stylu życia. Jako wykwalifikowany dietetyk z wieloletnim doświadczeniem, postanowiłem dzielić się wiedzą, która pomaga ludziom żyć pełniej i zdrowiej. Moja misja to dostarczanie rzetelnych, opartych na badaniach informacji o żywieniu, fitnessie i zdrowiu psychicznym. Wierzę, że każdy ma prawo do dostępu do wiedzy, która może znacząco poprawić jakość życia. Dążę do tego, by mój portal był miejscem, gdzie czytelnicy znajdą praktyczne porady, inspiracje oraz wsparcie w dążeniu do lepszego zdrowia.

Co to rzs? Dowiedz się, czym jest reumatoidalne zapalenie stawów - przewlekła choroba autoimmunologiczna atakująca tkanki stawowe. Sprawdź definicję, przyczyny, objawy i leczenie rzs

Poznaj charakterystykę i objawy ADHD u dzieci. Co to ADHD? Jak rozpoznać to zaburzenie neurorozwojowe? Przyczyny, rodzaje i skuteczne metody leczenia nadpobudliwości psychoruchowej.

Co to jest colostrum? Odkryj sekret pierwszej, cennej cieczy wydzielanej przez matkę po porodzie. Colostrum to źródło przeciwciał, witamin i składników odżywczych optymalnych dla niemowląt i dorosłych

Odkryj, jak filmy kształtują nasze nawyki żywieniowe. Poznaj inspirujące filmowe portrety prozdrowotnych przeobrażeń, wpływ kina na edukację dietetyczną i promowanie świadomych wyborów.

Kandydoza to zakażenie grzybicze wywoływane przez drożdżaki Candida. Poznaj jej przyczyny, charakterystyczne objawy oraz metody leczenia. Czym jest kandydoza i jak ją rozpoznać?

Zmagasz się z uporczywym zapaleniem pochwy? Poznaj skuteczne metody leczenia, w tym domowe sposoby oraz porady lekarskie. Co na zapalenie pochwy - pełne informacje

Rozpoznaj prawdziwą przyczynę bólu brzuszka dziecka i skutecznie mu przeciwdziałaj. Poznaj domowe sposoby na ból brzucha u 2-latka oraz sytuacje wymagające wizyty u lekarza. Co na ból brzucha u dwulatka działa najlepiej?

Jeśli Twoje dziecko cierpi na częste bóle brzucha, poznaj sprawdzone domowe sposoby na złagodzenie tego problemu. Skuteczne metody takie jak okłady, ziołowe masaże czy napary z rumianku pomogą ukoić co na ból brzucha u 4 latka.
Dowiedz się więcej o groźnych clostridium bakteriach, ich chorobotwórczych gatunkach, toksynach, objawach zakażenia, sposobach leczenia i zapobiegania tężcowi, botuliźmie czy zapaleniu jelit wskutek clostridium difficile.

Poznaj niesamowite korzyści, jakie dają probiotyki dla Twojego zdrowia. Co dają probiotyki? Wzmocnienie układu odpornościowego, lepsze trawienie i zdrowa mikroflora jelitowa to tylko niektóre z ich licznych dobrodziejstw.